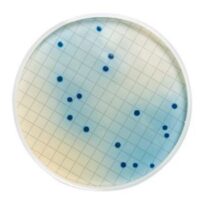

Description
Synonyms: 4-Methylumbelliferyl-β-D-glucuronide, 4-Methylumbelliferyl-β-D-glucuronide Supplement, MUGlcU
Empirical Formula (Hill Notation): C16H16O9
Application
Fluorogenic substrate for measuring of ß-glucoronidiase activity, for identifiacation of Escherichia coli.
Components
(per vial, sufficient for 500 ml medium)
4-Methylumbelliferyl ß-D-glucuronide (MUG) 50.0 mg
4-Methylumbelliferyl ß-D-glucuronide (MUG) 50.0 mg
PROPERTIES
sterility
sterile
Pack Size
5 vials
form
powder
shelf life
limited shelf life, expiry date on the label
application(s)
agriculture
environmental
food and beverages
microbiology
storage temp.
2-8°C
suitability
Escherichia coli
coliforms

![Chloramphenicol Selective Supplement [Pack of 5 vials]](https://idealmedical.co.za/wp/wp-content/uploads/2022/09/591-chloramphenicol-supplement-200x200.jpg)

Reviews
There are no reviews yet.